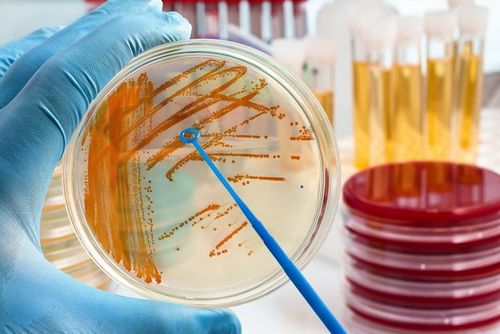

Počet elektromobilů v poslední době stoupá poměrně rychle. Jedním z důvodů je, že se jedná o dopravu bez výfukových zplodin, což oceňují především větší města. Zlé jazyky však tvrdí, že autům s klasickým motorem se nikdy nevyrovnají. Jak to tedy je s výkonností elektromobilů a jaké rychlosti mohou dosáhnout? Připravili jsme pro vás údaje o nejrychlejších osobních vozech, které pohání elektřina.

Otázku přepěťové ochrany mnozí z nás tak trochu podceňují a počítají s tím, že pravděpodobnost je statisticky poměrně nízká. Ale čert nikdy nespí a když se stane, že k přepětí v elektrické síti dojde, bývá pozdě na sypání si příslovečného popela na hlavu.

Jaderná elektrárna Temelín vyrábí levnou elektrickou energii od roku 2002. Seznamte se zajímavými fakty o této pozoruhodné stavbě.

Moderní domácnosti jsou plné technologií a elektroniky. Důležitou součást tvoří samozřejmě i mobilní zařízení – ať už jsou to tablety nebo chytré telefony. Neduhem těchto výkonných a multifunkčních přístrojů je ale nutnost poměrně častého nabíjení baterie. Zejména ve vícečlenné domácnosti, kde má každý alespoň jeden chytrý telefon, oceníte dostatek USB portů a možnost komfortního dobíjení.

Že elektrický pohon dokáže spolehlivě a hladce utáhnout i užitkové vozidlo vám jednoznačně dokáže nový Nissan e-NV200. Japonci se tentokrát vytáhli a na ničem nešetřili. Jejich elektro-dodávka je svižná, praktická, prostorná a přitom nabízí nenápadný, ale elegantní a přívětivý design.
Bakterie jsou obvykle považovány za něco nežádoucího a špatného. Bez některých, například střevních, se ale neobejdeme. Jako součást mikroflóry zajišťují správné fungování organismu. Že by nám ale bakterie mohly pomoci vyrábět elektrickou energii? Dost možná ano. A dokonce přímo ty, které si nosíme v těle.

Elektrokola jsou moderní a oblíbený dopravní prostředek. Současné modely už dokážou podávat velmi pěkné výkony a dopravit vás i na vzdálenost více než 100 km. Poradí si přitom i s obtížným terénem. Pokud o pořízení jízdního kola s elektromotorem uvažujete, máme pro vás návod, který vám pomůže s výběrem.

Klasický krb může sloužit jako zdroj tepla, ale i odpočinku při pohledu na oheň, ve kterém popraskává dřevo. Takovou romantiku by si chtěl občas dopřát snad každý, ale ne v každé domácnosti je možné mít skutečný krb. Elektrickou alternativu si oproti tomu můžete pořídit i do paneláku. Vyplatí se vám to?

Chcete jezdit ekologicky a komfortně, ale nedělat kolem toho humbuk? Volkswagen e-Golf vám to umožní. Tento tichý a nenápadný stroj splyne s běžným provozem, a pokud nejste znalec, od „normálního“ modelu Golf jej zběžným pohledem nerozeznáte. Design je prověřený a elegantní. Výkon, který se pod kapotou ukrývá je velmi příjemný.